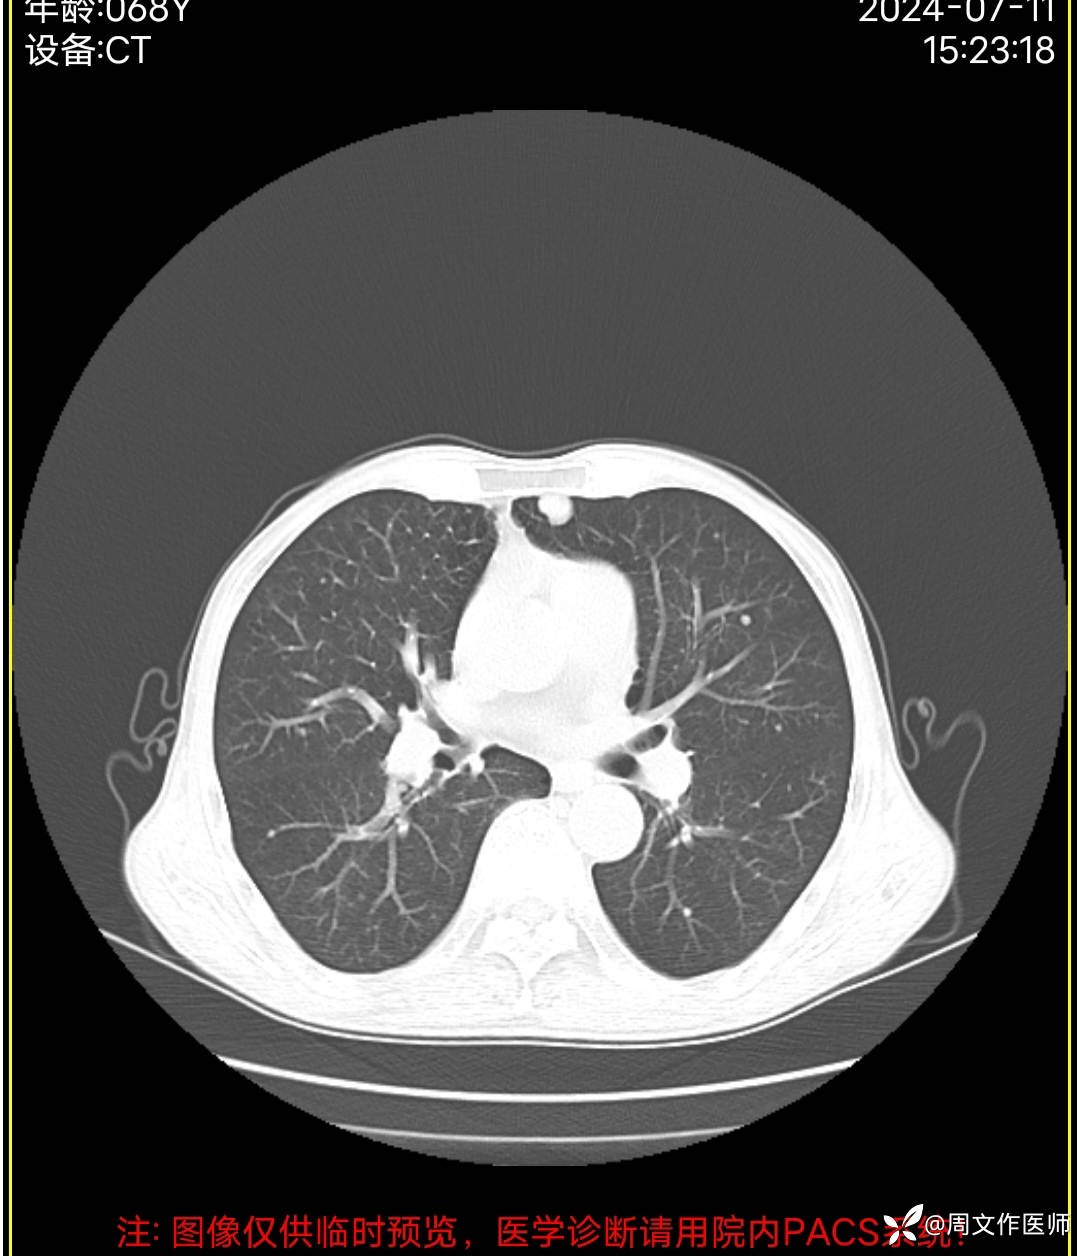
img

论健康体检的重要性:胃肠镜检查>40岁两年一检!车子检审亦如此为什么身体检查就不能呢
 丁香医小白 达人已点赞
丁香医小白 达人已点赞病例信息
患者男性,68岁,主诉:发现肛门肿物伴出血4年余,加重1月。
现病史:患者诉4年前发现肛门肿物,无疼痛等不适,未引起重视,2年前出现疼痛、出血,脓血溢出至我科住院治疗,完善相关检查确诊直肠癌并发多器官转移至肿瘤科化疗14次,2024年3月因直肠癌肿坏疽穿孔并弥漫性腹膜炎、肠梗阻在外院行 Hartmann手术;病情好转后出院,1月前感肛门肿物逐渐增大,出血及疼痛加重。今日到我院就诊,门诊以"1.肛门肿物;2.便血"收住入院。目前症见:肛门肿物突起,伴疼痛、出血,偶有脓血溢出。病程中患者精神、纳眠稍差,二便正常。体重下降5公斤。
既往史:平素身体健康状况差,有"直肠癌坏疽穿孔并弥漫性腹膜炎、腹壁切口裂开、肠梗阻、感染中毒性休克、直肠高分化腺癌 cT3NxM1+ IVa期、胃中-高分化腺癌、肝继发性恶性肿瘤、肺结节性质待查(转移瘤?)、低蛋白血症、电解质代谢紊乱、肝囊肿、慢性支气管炎伴肺气肿、动脉硬化、手足综合征"病史。否认心脑胸血管疾病,否认肾脏疾病,否认内分泌系统疾病,否认糖尿病,否认高血压,否认冠心病,否认“肝炎、结核、菌痢、伤寒”等传染病史,2024年3月在外院行 Hartmann手术、切口裂开缝合术;否认输血、外伤史,否认食物、药物过敏史,预防接种史不祥。
处理分析
入院检查图片

2024年3月Hartmann手术病理结果:

实验室检查




胸部CT检查

腹部增强CT检查







MRI检查






总结与讨论
讨论:1.健康中国行,论定期体检的重要性?
2、该病例下一步治疗方案?目的是什么?
















































